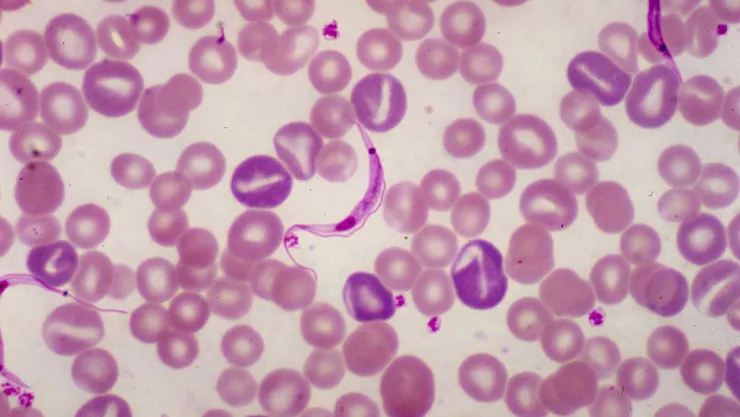
Trypanosoma Lewisi

Más de un millón de personas viven con mal de Chagas en México, lo que representa una importante carga económica para el país debido a la falta de diagnóstico y tratamiento oportuno, afirmó la especialista en medicina interna, Viviam Ubiarco.
Señaló que en su etapa crónica la enfermedad representa un pérdida de aproximadamente 18.5 años de vida productiva, tomando en cuenta que la expectativa media de edad son 74 años.
La enfermedad se contrae cuando las heces de chinches infectadas con un parásito entran en contacto con ojos, boca o lesiones cutáneas abiertas. Existen, sin embargo, otras formas de infección como transfusión sanguínea, trasplante de órganos y la contaminación congénita.
es un padecimiento silencioso y, en la mayoría de los casos, asintomático, lo que provoca que su diagnóstico se dé en etapas crónicas y no curables. Algunos de los síntomas que pueden llegar a presentarse son fiebre, fatiga, pérdida de apetito, dolor de cabeza y vómito.
Sigue la información dónde quiera que estés. ¡Descarga nuestra app!
erv